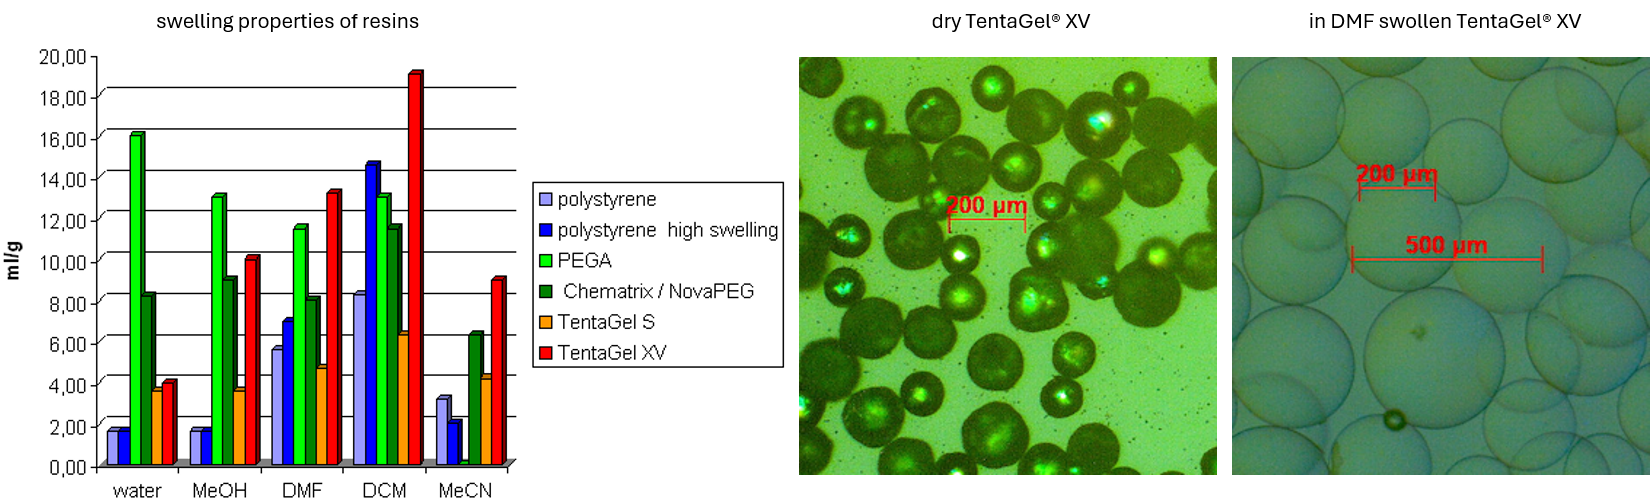

Technical Support
General Information of TentaGel® Resins
A technical overview
· TentaGel® is a trademark of Rapp Polymere GmbH.
· TentaGel® describes a whole family of resins.
Description
TentaGel® resins are grafted copolymers consisting of a low crosslinked polystyrene matrix on which poly (ethylene glycol) (PEG or POE) is grafted. As PEG is a "chameleon type" polymer with hydrophobic and hydrophilic properties, the graft copolymer shows modified physicochemical properties.
There are in principle two ways to introduce PEG onto the modified polystyrene matrix. The simplest immobilization procedure is to couple PEG via one of its terminal hydroxyl groups to chloromethylated polystyrene according to the classical ether synthesis or to use other bifunctional PEGs for coupling onto the solid support. However, when long chain PEGs (>800 Dalton) are used, the yields of this approach are unsatisfactory. Moreover, the homo-bifunctional PEGs react to a large extent at both ends to give cyclic poly (ethylene glycol) and additional crosslinking which can not be controlled. Consequently the number of free functions will be reduced with concomitant lowering of the capacity of the graft copolymer.
We have found that by means of anionic graft copolymerization setting up the PEG step by step directly on the matrix, PEG chains of molecular masses up to 20 kilo Dalton have been immobilized on functionalized crosslinked polystyrenes. Graft copolymers with PEG chains of about 2000-3000 Dalton proved to be optimal in respect of kinetic rates, mobility, swelling and resin capacity. As there is no procedure to get monodisperse PEG with more than 10 ethylene oxide units by any polymerization techniques, there is theoretically no way to introduce monodisperse PEG chains with more than 10 ethylene oxide units to the resin or to get monodisperse PEG by direct polymerization onto the polystyrene backbone (monodisperse is here defined as: PEG without any molecular weight distribution). Our process guarantees a very narrow molecular weight distribution of the grafted PEG spacers. These graft copolymers are pressure stable and can be used in batch processes as well as under continuous flow conditions.
Figure 1 illustrates the chemical architecture of the tentacle polymer. The copolymer contains about 50 - 70 % PEG (w/w). Therefore, the properties of these polymers are highly dominated by the properties of PEG and no longer by the polystyrene matrix.

Figure 1: chemical architecture of the tentacle polymer.
Swelling
This new physico chemical behavior is especially shown by the very consistent and almost solvent-independent swelling of the graft copolymer in comparison to 1% crosslinked polystyrene. See Tables and Structures
The PEG-graft copolymer swells in all solvents which dissolve PEG and, on the other hand, swelling is negligible in solvents which do not dissolve PEG, e.g. aliphatic hydrocarbons and diethyl ether. This broad range of usable good swelling solvents allows the use of TentaGel® resins in almost all solvent systems. Thus, after a reaction e.g. in methylene chloride, a solvent gradient can be used, e.g. from methylene chloride via tetrahydrofurane to aqueous systems, and then back from this hydrophilic system via a gradient to pure organic solvent systems, e.g. from water via tetrahydrofurane or ethanol to toluene.
Kinetics
The reactive sites which are located at the end of the spacer arms behave kinetically like in solution. This could be demonstrated by kinetic measurements where the coupling constants of the Boc-Gly-ONp active ester to both, low molecular mass compounds and graft copolymer, are in the same order of magnitude. Because of the flexibility and the good solvation properties of the PEG-tentacles polymer supported reactions could be performed on the solid support under quasi homogeneous conditions.
NMR
The 13C NMR relaxation time measurements (T1) also indicate the high flexibility of the PEG-spacers and the reactive sites at the end of the spacer. The NMR signals show a very narrow linewidth which is comparable to that of small molecules. This physicochemical property of the resin allows the use of 13C NMR and MAS 1H NMR spectroscopic techniques for investigations of the resin, for analysis of resin-bound molecules and resin functionality.
Particle size
Setting up a chemical library or peptide library by the "one bead one compound" approach it is essential to know the number of beads which are available within a certain amount of resin as well as the capacity of single beads. Table 1 summarizes some particle sizes and correlates them to the corresponding capacity of a single bead. The calculations are based on a typical loading of TentaGel®
beads which are in the range of 0.25 - 0.3 mmol/g. For analytical characterization at least 5 pmol of resin-bound peptide are needed for sequencing on a bead. In order to estimate the optimum resin quantity for the library which can be handled economically one has to take into account the bead sizes and bead capacities. In respect to homogeneity of diffusion process and kinetic rates as well as for single bead analysis and single bead quantification, all our beads show a very narrow size distribution.
See Tables and Structures of Base Resins.
The TentaGel® Family
There are several types of TentaGel® resins available showing tailored properties dependent on their application:
TentaGel® S resin
The PEG spacer is attached to the polystyrene backbone via an alkyl linkage. This linkage is not sensitive towards acids or bases. This type of resin is a standard type of resin used for peptide synthesis, solid phase organic synthesis or combinatorial chemistry.
TentaGel® R resin
The PEG spacer is attached to the polystyrene backbone via an alkyl linkage. This linkage is not sensitive to acids or bases. The resin is special suited for research purpose synthesis. It shows an increased swelling volume but is less pressure resistant. This makes the resin an ideal support for large peptides and difficult sequences.
TentaGel® HL resin
The PEG spacer is attached to the polystyrene backbone via an alkyl linkage. This linkage is not sensitive to acids or bases. This highloaded version of TentaGel® combines a significant higher capacity with the advantages of TentaGel® resins.
TentaGel® M resin
The PEG spacer is attached to the polystyrene backbone via an alkyl linkage. This linkage is not sensitive towards acids or bases. This resin is microspherical and with a narrow particle size distribution and was developed for applications in automated sorters, for creating huge libraries, for high speed synthesis etc.
TentaGel® MB resin
The PEG spacer is attached to the polystyrene backbone via an alkyl linkage. This linkage is not sensitive towards acids or bases. The macrobead resin shows extraordinary large particle diameters and high capacities and is designed for single bead synthesis, single bead analysis and single bead assays.
TentaGel® B resin
The PEG spacer is attached to the polystyrene backbone via an alkyl linkage. This linkage is not sensitive to acids or bases. This resin type exists in two bifunctional species:
• Surface modified resins: the reactive sites on the outer surface of the beads are protected orthogonally to the reactive sites in the internal volume of the beads.
• Hybrid resins: cleavable and noncleavable ligands are present in this support – developed for sequentional cleavage.
TentaGel® XV resin
TentaGel® XV resin (XV stands for “extended swelling volume”) is a new member of the TentaGel®
family. Modifications on the polystyrene backbone changes the swelling properties of the PEG grafted resin.
Swelling properties are in the same range or even higher compared to PEGA or Chematrix resins. The polar PEG spacers allow the composite resin to swell in a wide range of solvents including water, methanol, DMF, DCM. Nevertheless, the handling is still very easy and similar to other TentaGel® resins.
Figure 2: detailed swelling information of the TentaGel® XV.
TentaGel® N resin
These tailored resins are used in oligonucleotide chemistry for small and large scale oligonucleotide synthesis. In comparison to CPG glass the capacity is increased by a factor of 10. Special coupling protocols are needed.
TentaGel® PAP resin
The PEG spacer is attached to the polystyrene backbone via a benzyl ether linkage. This benzyl ether linkage is sensitive to harsh acid conditions like 100 % TFA or mixtures of TFA/trimethylsilyl bromide.
This specially tailored resin is used for immunization procedures or for synthesizing PEG modified derivatives (PEG Attached Peptides, PEG-modified compounds). Using strong acid conditions, the PEG spacer is cleaved from the solid support together with the synthesized compound. Thus, soluble PEG modified compounds ( e.g. PEG modified peptides) are synthesized by applying solid phase methods.
TentaGel® MAP resin
This resin is ideally suited for the synthesis of uncleavable resin-linked Multiple Antigenic Peptides (MAPs). The MAP peptides are immobilized on the resin and withstand TFA treatment. These resins have been developed for the use as polymeric immunoconjugates. They show no resin dependent adverse effects during immunization.
TentaGel® RAP resin
This resin is ideally suited for the synthesis of uncleavable resin-linked peptides (Resin Attached Peptides). These resins have been developed for the use as polymeric immunoconjugates. They show no resin dependent adverse effects during immunization.
General Comments
As TentaGel® resins are copolymers composed from polystyrene and poly (ethylene glycol), chemical and physicochemical properties of both base polymers have to be taken in account.
PEG itself is a hygroscopic polymer. It is known from literature that PEG esters are not very stable and easily hydrolyzed. Dependent on the storage conditions and storage time, PEG itself can be oxidized along the polyether chain to form peroxides or esters. Consequently, acid treatment or treatment with bases hydrolyzes the formed PEG-esters which result in a small amount of "PEG - leakage". This leakage can be noticed by MS or NMR as PEG signals and impurities in the final product. This chemical behavior is true to all PEGs and PEG based polymers.